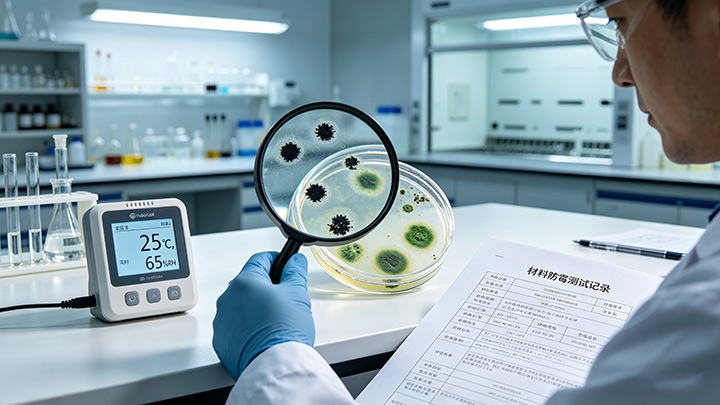
材料防霉检查

核心摘要:工业产品发霉不仅导致产品报废、经济损失,还会影响品牌信誉,尤其出口型工厂需应对不同地区合规要求。本文从工厂生产全流程出发,结合我司防霉抗菌解决方案的经验,详解工业产品防霉的核心方法、操作标准及常见误区,助力工厂降低发霉损耗,提升产品合格率。
一、工业产品发霉的核心诱因
工业产品发霉的本质是霉菌在适宜环境中滋生繁殖,其核心诱因与工厂生产、仓储、运输全环节密切相关,也是后续防霉措施的核心针对点。

1.1 环境诱因
霉菌生长需满足温度20-35℃、湿度>60%、氧气充足三个条件,不同地域需针对性调整:
-
热带/亚热带地区(如东南亚、华南):全年高温高湿,仓储环境湿度易超标,是发霉重灾区,需重点做好除湿、通风;
-
温带地区(如华东、华北):雨季(6-8月)湿度骤升,需临时强化防霉措施;
-
出口海运场景:集装箱密闭环境易形成“冷凝水”,导致产品受潮发霉,需适配国际运输合规要求。
1.2 产品自身诱因
部分工业产品材质易吸附水分、富含营养物质,成为霉菌“天然温床”,常见于:
-
纺织类工业产品(如工业布料、劳保服):纤维易吸湿,储存不当易发霉;
-
塑料/橡胶类产品(如塑胶配件、密封圈):表面易凝结水汽,尤其是再生料产品防霉性更弱;
-
金属类产品(如五金配件、机械设备):表面锈蚀产生的水分,会间接诱发霉菌生长;
-
包装材料(如纸箱、木质托盘):未干燥彻底或存储环境潮湿,会直接污染产品。
1.3 生产流程诱因
工厂生产环节的操作疏漏,是导致产品发霉的隐形诱因,易被忽视:
-
原料采购:原料本身携带霉菌孢子,未经过防霉检测直接入库;
-
生产加工:生产过程中产品表面残留水分、油污,未彻底干燥即进入下一道工序;
-
包装环节:包装材料未干燥、包装密封性能差,导致外界湿气进入;
-
仓储运输:仓储堆放过密、通风不畅,运输过程中温湿度波动过大。
二、工厂工业产品防霉完整流程
结合工厂生产全流程,从“源头控制-过程管控-仓储运输-检测复盘”四大环节,给出可落地的防霉方案,适配不同规模工厂需求。
2.1 源头控制:原料采购与预处理(从根源减少霉菌风险)
2.1.1 原料采购防霉要求
-
建立供应商防霉审核机制,要求供应商提供原料防霉检测报告,重点检测霉菌孢子含量;
-
优先采购防霉性能优异的原料,如添加防霉剂的塑料粒子、经过防霉处理的纺织原料;
-
避免采购受潮、结块、有霉斑的原料,入库前进行抽样检测,不合格原料严禁入库。
2.1.2 原料预处理防霉操作
-
固体原料(如塑料粒子、五金原料):入库前放在通风干燥区域晾晒/烘干,确保含水量≤10%;
-
纺织原料:采用高温烘干处理,烘干后立即密封包装,防止二次受潮;
-
包装材料(纸箱、托盘):提前在干燥房存放72小时以上,确保含水量≤12%,避免使用受潮包装。
2.2 过程管控:生产环节防霉(核心环节,降低发霉概率)
2.2.1 生产车间环境管控
-
安装温湿度监控设备,实时监控车间温湿度,确保温度控制在18-25℃,湿度≤55%;
-
高温高湿地区(如华南、东南亚工厂):安装工业除湿机、新风系统,雨季增加除湿频次,每天定时通风2-3次,每次30分钟以上;
-
车间地面、墙面做好防潮处理,避免地面积水,定期清洁车间,减少霉菌孢子滋生环境;
-
生产设备定期清理,避免设备表面残留水分、油污,防止霉菌附着繁殖。
2.2.2 产品加工过程防霉操作
-
纺织类产品:染色、印花后彻底烘干,烘干温度控制在80-100℃,烘干时间根据产品厚度调整,确保产品含水量≤8%;
-
塑料/橡胶类产品:注塑、硫化后进行冷却干燥处理,避免产品表面凝结水汽,冷却后立即包装;
-
金属类产品:加工完成后进行防锈处理(如喷涂防锈漆、涂抹防锈油),避免锈蚀产生水分;
-
产品加工过程中,避免裸手直接接触产品,操作人员佩戴一次性手套,减少汗液污染。

2.2.3 包装环节防霉(关键防护,隔绝外界湿气)
-
采用密封性能优异的包装材料,如真空包装、铝箔包装,避免外界湿气进入;
-
包装内放置Power Dryer防霉干燥剂(矿物干燥剂),根据包装体积合理放置,一般每1立方米放置200g防霉干燥剂;
-
包装过程中,确保产品表面干燥、无油污、无霉斑,包装后立即密封,避免二次受潮;
-
出口产品包装:根据出口目的地气候,选择适配的包装方案,如出口东南亚地区,增加干燥剂用量,采用双层密封包装。

2.3 仓储运输:成品防护(避免成品发霉)
2.3.1 仓储环境防霉管控
-
仓储库房选择地势较高、通风良好的区域,库房地面铺设防潮垫,墙面涂刷防潮涂料;
-
安装工业除湿机、温湿度监控设备,保持库房湿度≤55%,温度15-25℃,定期检查温湿度记录;
-
成品堆放规范:堆放高度不超过2米,与墙面、地面保持30cm以上距离,避免堆放过密,确保通风顺畅;
-
定期使用iHeir-Spray仓库防霉剂对库房进行清洁、消毒,每月至少消毒1次,采用防霉杀菌剂(如二氧化氯),避免霉菌孢子滋生;
-
不同类型产品分开存放,避免交叉污染,尤其是易发霉产品(如纺织、塑料)单独存放。

2.3.2 运输环节防霉管控
-
选择有防潮、通风功能的运输车辆,运输前检查车辆内部是否干燥、有无霉斑;
-
海运出口产品:采用集装箱运输时,在集装箱内放置除湿袋、T-1000集装箱干燥剂,密封集装箱前检查集装箱内壁是否有冷凝水,必要时进行烘干处理;
-
运输过程中,避免车辆暴晒、淋雨,控制运输环境温湿度,减少温湿度波动;
-
短途运输:避免成品裸露放置,采用密封包装,运输时间尽量缩短,尤其是高温高湿天气。
2.4 检测复盘:定期排查与优化(持续提升防霉效果)
-
建立成品防霉检测机制,入库前、出库前对成品进行抽样检测,检测霉菌孢子含量,不合格产品严禁入库、出库;
-
定期对生产、仓储、运输环节进行排查,发现发霉隐患(如湿度超标、原料受潮)及时处理;
-
针对发霉案例进行复盘,分析发霉原因,优化防霉措施,尤其是针对不同地域的差异,调整防霉方案;
-
定期对操作人员进行防霉培训,规范操作流程,提升防霉意识。

三、不同类型工业产品针对性防霉方案
不同材质工业产品发霉特性不同,结合其材质特点,给出针对性防霉方案,提升防霉方案实用性:
3.1 纺织类工业产品(如工业布料、劳保服、帐篷)
-
原料预处理:采用防霉纺织助剂,在染色过程中添加,提升纺织原料自身防霉性能;
-
生产加工:烘干后进行防霉喷涂处理,采用环保型防霉剂,避免残留;
-
包装仓储:采用真空包装,内置硅胶干燥剂,仓储环境保持干燥,避免阳光直射。
3.2 塑料/橡胶类工业产品(如塑胶配件、密封圈、玩具)
-
原料采购:选择添加防霉剂的塑料粒子、橡胶原料,拒绝再生料(再生料易发霉);
-
生产加工:注塑、硫化过程中添加适量防霉剂,提升产品防霉性能;
-
包装仓储:采用密封包装,避免产品表面接触湿气,仓储环境湿度控制在50%以下。
3.3 金属类工业产品(如五金配件、机械设备、模具)
-
加工后处理:喷涂防锈漆、涂抹防锈油,隔绝空气和水分,避免锈蚀;
-
包装仓储:采用防潮包装,内置干燥剂,仓储环境保持干燥,避免潮湿锈蚀;
-
长期存放:定期检查,及时补充防锈油,避免霉菌滋生。
3.4 出口型工业产品
-
了解出口目的地气候特点,针对性调整防霉方案(如东南亚地区强化防潮,欧美地区注重环保防霉剂使用);
-
符合国际防霉合规要求,使用环保型防霉剂,提供防霉检测报告,避免因防霉剂超标被拒收;
-
海运包装:采用双层密封包装,增加干燥剂用量,在集装箱内放置温湿度记录仪,便于追溯。
四、工厂防霉常见误区(避坑指南)
很多工厂在防霉过程中存在操作误区,反而增加产品发霉概率,以下是最常见的4个误区
-
误区1:只注重成品防霉,忽视原料预处理 → 原料携带霉菌孢子,后续再怎么处理,也难以彻底杜绝发霉;
-
误区2:过度依赖干燥剂,忽视环境除湿 → 干燥剂只能吸收局部水分,环境湿度超标时,干燥剂很快失效;
-
误区3:认为“高温就能杀菌”,忽视干燥环节 → 高温只能杀死部分霉菌孢子,若产品未彻底干燥,霉菌仍会滋生;
-
误区4:出口产品只做国内防霉标准,忽视地域差异 → 不同地区气候不同,防霉要求不同,易导致出口产品发霉拒收。
五、总结:工厂工业产品防霉核心要点
工业产品防霉的核心是“全流程管控、针对性防护、地域适配”,本质是控制霉菌生长的温湿度、营养源两个关键因素。工厂需从原料采购、生产加工、仓储运输、检测复盘四个环节入手,结合自身产品类型与出口地域特点,制定可落地的防霉方案,既能降低产品发霉损耗,又能提升产品竞争力,避免因发霉导致的经济损失与品牌影响。
温馨提示:若需根据具体工业产品类型(如纺织、五金)、出口地域(如东南亚、欧美),定制专属防霉方案,可留言咨询,获取一对一指导。




